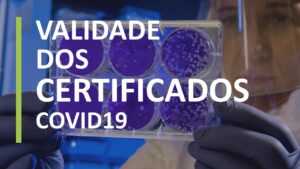

Validade dos certificados – COVID 19
A data da auditoria da tua empresa aproxima-se e o país está em pleno estado de emergência nacional por causa da pandemia do COVID-19. O
A data da auditoria da tua empresa aproxima-se e o país está em pleno estado de emergência nacional por causa da pandemia do COVID-19. O

Um dos requisitos novos do BRC Food versão 8 é ponto 5.8 Pet Food ou alimentos para animais de estimação. Este requisito pode levantar muitas

Já aconteceu fazer auditorias a fornecedores e deparar-me com este cenário: Seleciono uma encomenda aleatória e faço uma auditoria vertical, onde vejo rastreabilidade, controlos dos

Na empresa existe uma cantina onde servem refeições aos funcionários? Não têm? E se apenas estiver à disposição dos funcionários uma máquina de venda automática

Já estiveram no Canadá durante o Inverno? Eu nunca tive, mas posso dizer que estive exposta a temperaturas parecidas ao inverno no Canadá. Foi arrepiante!!!

Ainda falando de tempo de vida de prateleira. Ficaram esclarecidos com o primeiro vídeo? Espero que sim. Neste vídeo (parte 2) vou então falar sobre

As reuniões pode ser uma dor de cabeça para muitas pessoas. A primeira dor de cabeça é planear as reuniões e que todos os convocados

Existem dois requisitos que abordam o tema do tempo de vida de prateleira dos produtos. Será que são requisitos repetidos ou são coisas diferentes. Vou

Sabia que: há mais 3 formas de controlo para além da auditoria de certificação normal?

A trabalhar na área de segurança alimentar não podemos ser ingénuos no que pode contaminar e adulterar os alimentos, por isso fica um excerto para